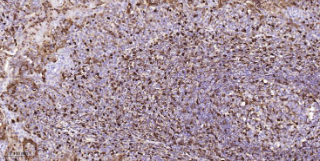

Human S100A4 Ready-To-Use IHC Kit
Human S100A4 Ready-To-Use IHC Kit
Cat. No.: IHC0661HSample Type: FFPE tissue
Size: 50T (including a control slide)
Storage and Stability: Please store components at the temperatures indicated on the individual tube labels. The kit is stable for 6 months from the date of receipt.
Background
The protein encoded by this gene is a member of the S100 family of proteins containing 2 EF-hand calcium-binding motifs. S100 proteins are localized in the cytoplasm and/or nucleus of a wide range of cells, and involved in the regulation of a number of cellular processes such as cell cycle progression and differentiation. S100 genes include at least 13 members which are located as a cluster on chromosome 1q21. This protein may function in motility, invasion, and tubulin polymerization. Chromosomal rearrangements and altered expression of this gene have been implicated in tumor metastasis. Multiple alternatively spliced variants, encoding the same protein, have been identified.
Synonyms
18A2; 42A; CAPL; FSP1; metastasin; MTS1; P9KA; PEL98; pk9a; RNP9KA; S100A4.Validation Data
Materials Supplied
| Number | Component | 50T | Concentration | Storage |
|---|---|---|---|---|
| 1 | PBS Buffer (powder) | 2L x 2 | 20x | RT |
| 2 | Antigen Retrieval Buffer | 20ml | 100x | 2-8°C |
| 3 | Endogenous Peroxidase Blocking Buffer | 3ml | RTU | 2-8°C |
| 4 | Blocking Buffer | 3ml | RTU | 2-8°C |
| 5 | Primary Antibody (Human S100A4 Recombinant Rabbit mAb) | 6ml | RTU | 2-8°C |
| 6 | Secondary Antibody (Goat Anti-Rabbit IgG H&L, HRP conjugated) | 6ml | RTU | 2-8°C |
| 7 | Chromogen Component A | 0.3ml | RTU | -20°C |
| 8 | Chromogen Component B | 0.3ml | RTU | -20°C |
| 9 | Counter Staining Reagent | 5ml | RTU | RT |
| 10 | Differentiation Reagent | 6ml | RTU | RT |
| 11 | Mounting Media | 5ml | RTU | RT |
| 12 | Control slide (Human tonsil) | 1 slide | RTU | RT |
| 13 | Datasheet | 1 copy |
Notes
- The positive control slide provided in the kit allows you to be sure that the experimental set-up is working properly.
- Do not allow slides to dry at any time during this procedure.
- Please don't replace the matching reagents in this product with other manufacturers' products.
- As DAB is a carcinogen, please take necessary precautions.
- PBS (reagent 1) can be stored for one week at 4℃ after preparation; The antigen retrieval buffer (1×reagent 2) and the chromogenic agent (the mixture of reagents 7 and 8) should be prepared right before each assay.
As DAB is a carcinogen, please take necessary precautions.
Important Note: This product as supplied is intended for research use only, not for use in human, therapeutic or diagnostic applications.